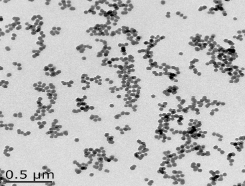
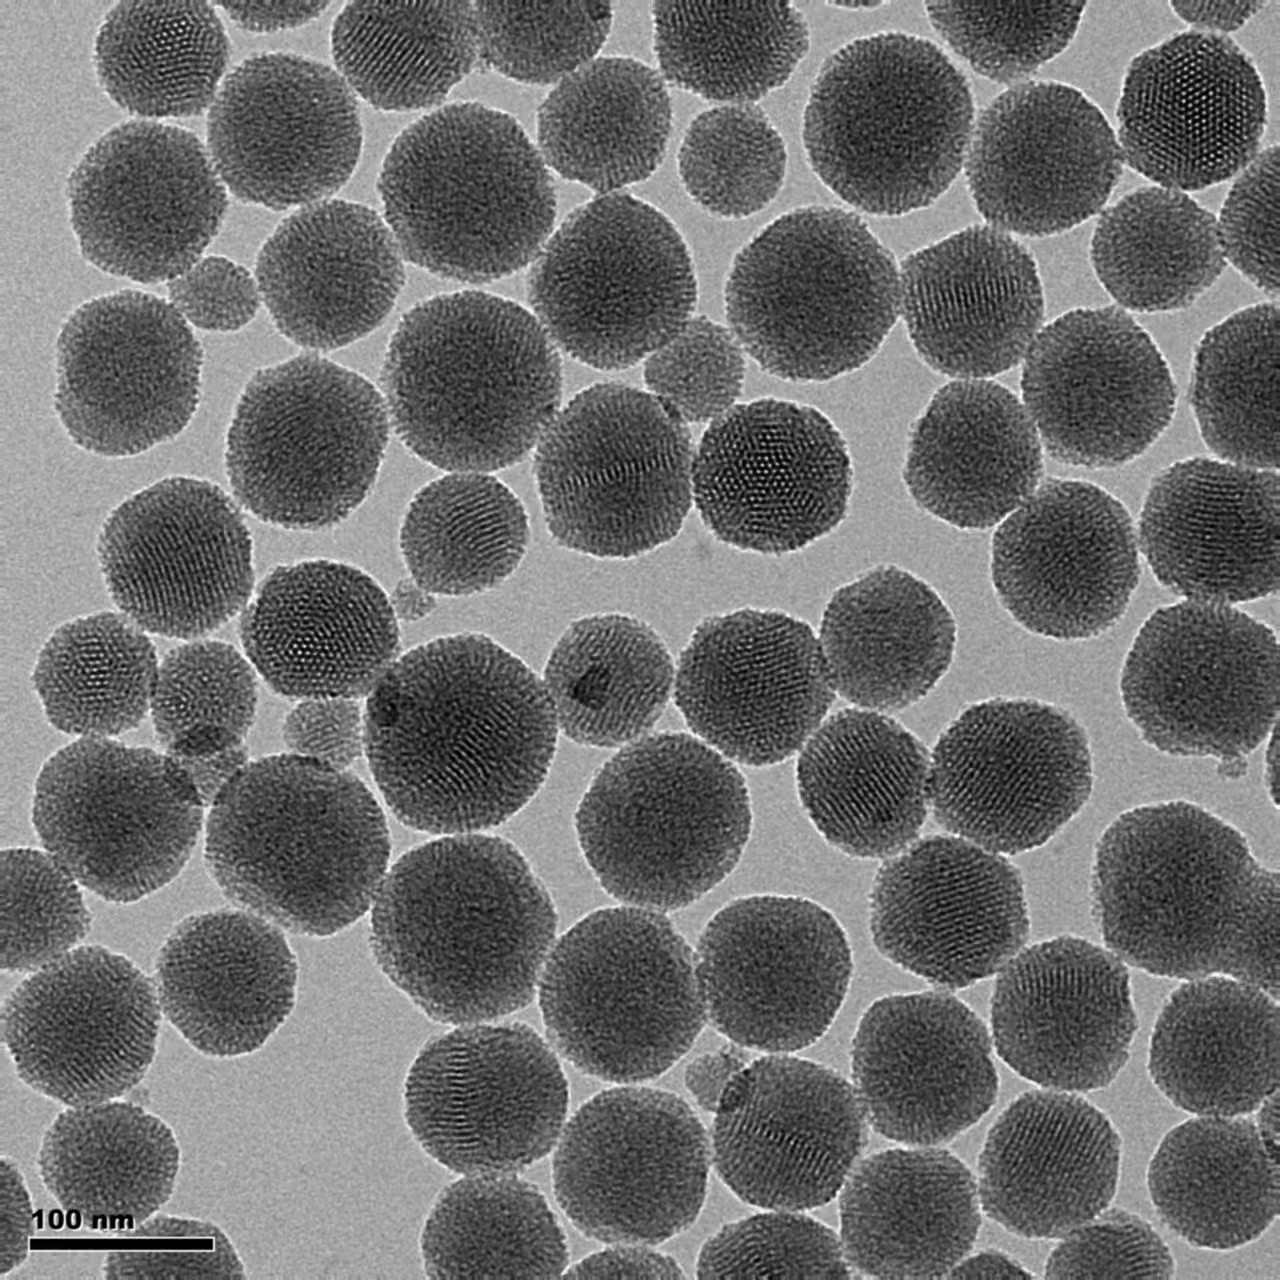
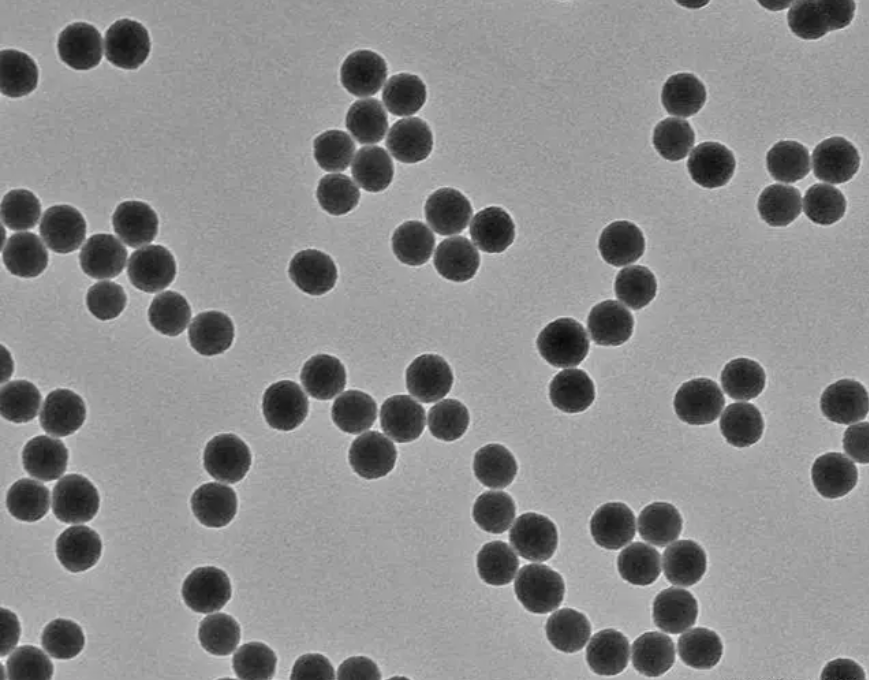

氨基磁性介孔二氧化硅纳米颗粒
中文名称:氨基磁性介孔二氧化硅纳米颗粒
英文名称:Amino magnetic mesoporous silica nanoparticles
成分:单分散磁性介孔二氧化硅纳米颗粒/纯水
浓度:5 mg/mL
货号:L-212145
价格:联系客服询优惠报价
概述
【产品名称】
氨基磁性介孔二氧化硅纳米颗粒
【产品详情】
我司提供单分散磁性介孔二氧化硅纳米颗粒系列产品,是以超顺磁性的 Fe3O4为内核,介孔硅作为外壳的复合纳米颗粒。具有高度有序的介孔结构,良好的化学和热稳定性,以及表面富含大量易于修饰的羟基、氨基官能团等特性,被广泛应用于药物载体、生物催化、生物成像与传感器、疾病诊断、磁共振成像以及智能药物释放等生物医学领域。
【储存条件】
保存条件:密封,4℃/12 个月,禁止冷冻,使用前请充分混匀
保存溶液:纯水
备注:本公司所售产品仅用于科研,不能用于人体实验或人体治疗。
澳泷生物基于自主研发-生产-销售一体化的经营模式,公司产品与市场上同类产品相比,价格优势明显。
此外我们还提供专业化的产品定制服务。
客服电话:18392132620 QQ:1057786641
客服电话:13696562679 QQ:2370711501
客服电话:18716275738 QQ:2379635963